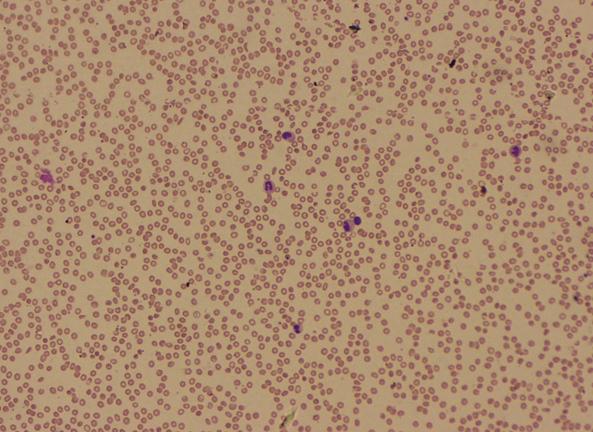

- Clinical Technology
- Adult Immunization
- Hepatology
- Pediatric Immunization
- Screening
- Psychiatry
- Allergy
- Women's Health
- Cardiology
- Pediatrics
- Dermatology
- Endocrinology
- Pain Management
- Gastroenterology
- Infectious Disease
- Obesity Medicine
- Rheumatology
- Nephrology
- Neurology
- Pulmonology
Disseminated Intravascular Coagulation as an Unusual Presentation of Acute Retroviral Syndrome
Multiple atypical presentations of acute retroviral syndromehave been reported in the literature, but rarely has acute retroviralsyndrome been associated with disseminated intravascularcoagulation (DIC). We detail a case of a 19-year-old manadmitted to the hospital with initially unexplained severe DICthat on workup was found to be secondary to acute retroviralsyndrome. [Infect Med. 2008;25:24-28]
The acute retroviral syndrome associated with primary HIV infection may present as a mild viral syndrome, a mononucleosis- like illness, or a severe multisystemic illness. The onset of the illness ranges from 1 to 6 weeks after exposure to the virus but peaks at 3 weeks. Overall, the frequency of symptomatic primary infection is unknown, but it has been estimated to occur in 30% to 70% of cases of HIV infection.1,2
Acute retroviral syndrome can be difficult to diagnose because of its nonspecific and protean manifestations. Even when a diagnosis is made, treatment is still considered optional. At present, there are limiteddata on the treatment of acute retroviral syndrome in patients with acute HIV infection, and trials are addressing questions about the longterm benefit of potent treatment regimens initiated during acute infection as well as the optimal duration of therapy.3,4
Case report
In January 2005, a 19-year-old African American man presented to the emergency department with a 1- week history of weakness and a 3- day history of hematuria, melena, epistaxis, and bleeding from the gums. He also reported fatigue, high-grade fever, and a nonproductive cough.
On presentation, the patient was febrile, with a temperature of 39.2C (102.5F). He also was hypotensive, with a blood pressure reading of 86/61 mm Hg. Pulse rate was 96 beats per minute, and respiratory rate was 20 breaths per minute. The patient had an erythematous pharynx with bilateral tonsillar enlargement. He did not have signs of hepatomegaly or splenomegaly but had heme-positive black stools on rectal examination.
The patient was not taking any medications. He had had an allergic reaction to diphtheria-pertussis-tetanus vaccine. His sexual history was significant for having 2 male sexual partners within the past 2 years. He denied alcohol, tobacco, and illicit injection drug use. His past medical history revealed no significant findings, and there was no family history of a bleeding disorder.
After admission, initial laboratory tests revealed a white blood cell count of 4.1 ? 109/L, with a normal differential; hemoglobin level of 13.6 g/dL; hematocrit value of 40.0%; platelet count of 96 ?109/L; prothrombin time of 14.7 seconds; and partial thromboplastin time of 46.8 seconds. Additional laboratory tests yielded the following results: international normalized ratio, 1.12; fibrinogen, 164 mg/dL; fibrin degradation products, greater than 40?g/mL; albumin, 2.6 g/dL; total protein, 4.8 g/dL; alanine aminotransferase, 21 U/L; aspartate aminotransferase, 110 U/L; and alkaline phosphatase, 46 U/L. Results of a mono test were negative.
The patient was directly admitted to the ICU and supportively managed for disseminated intravascular coagulation (DIC) after exclusion of other common causes of coagulopathy. An initial workup in the first 3 days after admission did not reveal a cause for DIC. Results from multiple blood, urine, and sputum cultures were negative, and a peripheral smear and bone marrow biopsy were performed to exclude hematological malignancy.
The peripheral blood smear showed teardrop cells; reduced platelet count; nucleated red blood cells; and hypolobulated, hypogranular neutrophils (Figure 1). A bone marrow biopsy specimen showed a mildly hypocellular marrow, moderate left shift with maturation, trilineage hematopoiesis, and presence of iron stores (Figure 2). Bone marrow routine culture, fungal culture, and mycobacterial culture were negative. HIV enzyme-linked immunosorbent assay (ELISA) was nonreactive twice, but because of the suspicion of acute HIV infection, an HIV-1 RNA polymerase chain reaction (PCR) test was performed. It demonstrated an HIV- 1 RNA level of 368,195 copies/mL. The patient had a CD4+ cell count of 62/?L, a CD8+ cell count of 157/?L, a CD3+ T-cell count of 242/?L, and a CD4:CD8 ratio of 0.39.
Figure 1
-
Low-power view of peripheral blood smearshowing normocytic hypochromic anemia with mildanisocytosis and poikilocytosis, reduced platelet count,and abnormal morphology of white blood cells.

Figure 2
-
Low-power view of bone marrow biopsyspecimen showing mildly hypocellular bone marrowwith trilineage hematopoiesis and moderate left shift.
Hematological parameters worsened, as evidenced by a fall in platelet count to 52?109/L and in hemoglobin level and hematocrit value to 8.5 g/dL and 24.1%, respectively, by the third hospital day (Figure 3). A rise was seen in prothrombin time, partial thromboplastin time, and international normalized ratio to 18.3 seconds, 55.2 seconds,and 1.49, respectively, by the second hospital day (Figure 4). In the ICU, the patient was given a transfusion of fresh frozen plasma, platelets, and packed red blood cell. Epistaxis was controlled with phenylephrine nasal spray and anterior nasal packing. Within 1 week, all symptoms had resolved. The platelet count, prothrombin time, and partial thromboplastin time normalized.

Figure 3
-
Thepatient's platelet count, hemoglobin (Hb) level, and hematocrit (Hct) value dropped by day 3 afteradmittance,but these parameters normalized after the patient was given a transfusion of plasma, latelets, and red blood cells.

Figure 4
-
Prothrombin time (PT) and partial thromboplastin time (PTT) increased by day 2 after admittance but normalizedwithin a week of therapeutic intervention.
Discussion
DIC is a clinicopathological syndrome of activated coagulation that manifests with bleeding or thrombosis. It is not a disease in itself; it is always secondary to an underlying disorder, such as infection, cancer, trauma, venom poisoning, heatstroke, burns, or obstetric catastrophe. The spectrum ranges from asymptomatic to chronic compensated DIC through multisystem organ failure to an acute fulminating bleeding diathesis.5,6
Infection is a common cause of DIC, and it can be caused by nearly any type of microorganism, usually by septicemic Gram-positive and Gram-negative bacteria as well as Rickettsia species, viruses, and parasites. Components of these microorganisms activate cytokines-chiefly tumor necrosis factor and interleukin- 6-inducing an inflammatory response and triggering the derangement of the coagulation system and DIC.7
Management of DIC has 2 general foci. First is the correction of the underlying trigger mechanisms in an effort to eliminate further activation of the coagulation cascade. Second is the vigorous replacement of missing blood components with platelets or plasma.6,7
The patient described in this case had DIC triggered by an underlying acute retroviral infection. DIC has been rarely reported as an initial presentation of HIV infection in the literature.8,9
Acute HIV infection is defined by detectable HIV RNA in plasma (levels of which are usually extremely high) by using sensitive PCR or branched DNA assays in the setting of a negative or indeterminate HIV antibody test result. Diagnosis of HIV infection made by HIV RNA testing should be confirmed by standard methods (ie, ELISA and Western blot testing) performed 2 to 4 months after the initial indeterminate or negative test result.
In investigating a possible infectious cause for DIC when findings from the initial workup are normal and culture results are negative, a diagnosis of acute retroviral syndrome must be considered, especially in patients who present with a viral syndrome and appropriate risk factors. Recognition of acute retroviral syndrome is important for the patient and for public health. It allows for modification of risk factors, prevention of subsequent transmission, and early initiation of antiretroviral therapy that could theoretically alter the natural course of the infection and delay disease progression.
References:
- Clark SJ, Shaw GM. The acute retroviral syndrome and the pathogenesis of HIV-1 infection. Semin Immunol. 1993;5:149-155.
- Huang ST, Lee HC, Liu KH, et al. Acute human immunodeficiency virus infection. J Microbiol Immunol Infect. 2005;38:65-68.
- Rosenberg E, Cotton D. Primary HIV Infection and the acute retroviral syndrome. AIDS Clin Care. 1997;9:19, 23-25.
- Guidelines for the Use of Antiretroviral Agents in HIV-1-Infected Adults and Adolescents. Availableat: http://aidsinfo.nih.gov/contentfiles/ AdultandAdolescentGL.pdf. Accessed October 24, 2007.
- Messmore H, Wehrmacher WH. Disseminated intravascular coagulation: a primer for primary care physicians. Postgrad Med. 2002;111. Available at: www.postgradmed.com/issues/ 2002/ 03_02/messmore.htm. Accessed October 24, 2007.
- Cho YS, Kim KW, Yang SN. Disseminated intravascular coagulation after a surgery for a mandibular fracture. J Oral Maxillofac Surg. 2001;59:98-102.
- Levi M, Ten Cate H. Disseminated intravascular coagulation. N Engl J Med. 1999;341:586-592.
- Fera G, Semeraro N, De Mitrio V, Schiraldi O. Disseminated intravascular coagulation associated with disseminated cryptococcosis in a patient with acquired immunodeficiency syndrome. Infection. 1993;21:171-173.
- Rheingold SR, Burnham JM, Rutstein R, Manno CS. HIV infection presenting as severe autoimmune hemolytic anemia with disseminated intravascular coagulation in an infant. J Pediatr Hematol Oncol. 2004;26:9-12.
2 Commerce Drive
Cranbury, NJ 08512
All rights reserved.